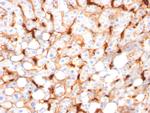
C1QB/Complement C1q B-Chain Antibody in Immunohistochemistry (Paraffin) (IHC (P))

Search
NeoBiotechnologies
C1QB/Complement C1q B-Chain Monoclonal Antibody (C1QB, 2966)
{{$productOrderCtrl.translations['antibody.pdp.commerceCard.promotion.promotions']}}
{{$productOrderCtrl.translations['antibody.pdp.commerceCard.promotion.viewpromo']}}
{{$productOrderCtrl.translations['antibody.pdp.commerceCard.promotion.promocode']}}: {{promo.promoCode}} {{promo.promoTitle}} {{promo.promoDescription}}. {{$productOrderCtrl.translations['antibody.pdp.commerceCard.promotion.learnmore']}}
产品信息
713-MSM6-P1ABX
种属反应
宿主/亚型
分类
类型
克隆号
抗原
偶联物
形式
浓度
规格
纯化类型
保存液
内含物
保存条件
运输条件
产品详细信息
Immunohistochemistry (PFA fixed): incubate antibody for 30 min RT. Staining of formalin-fixed tissues requires heating tissue sections in 10mM Tris with 1mM EDTA, pH 9.0, for 45 min at 95 degrees C followed by cooling at RT for 20 minutes.
靶标信息
C1QB is a major constituent of the human complement subcomponent C1q. C1q associates with C1r and C1s in order to yield the first component of the serum complement system. Deficiency of C1q has been associated with lupus erythematosus and glomerulonephritis. C1q is composed of 18 polypeptide chains: six A-chains, six B-chains, and six C-chains. Each chain contains a collagen-like region located near the N terminus and a C-terminal globular region. The A-, B-, and C-chains are arranged in the order A-C-B on chromosome 1.
仅用于科研。不用于诊断过程。未经明确授权不得转售。
篇参考文献 (0)
生物信息学
蛋白别名: C1QTNF5; complement 1-q subcomponent beta-chain; complement C1q chain B; Complement C1q subcomponent subunit B; complement component 1, q subcomponent, B chain; complement component 1, q subcomponent, beta polypeptide; complement component C1q, B chain; complement subcomponent C1q chain B; CTRP5; DKFZP586B0621; LORD
基因别名: C1QB; C1QD2
UniProt ID: (Human) P02746
Entrez Gene ID: (Human) 713